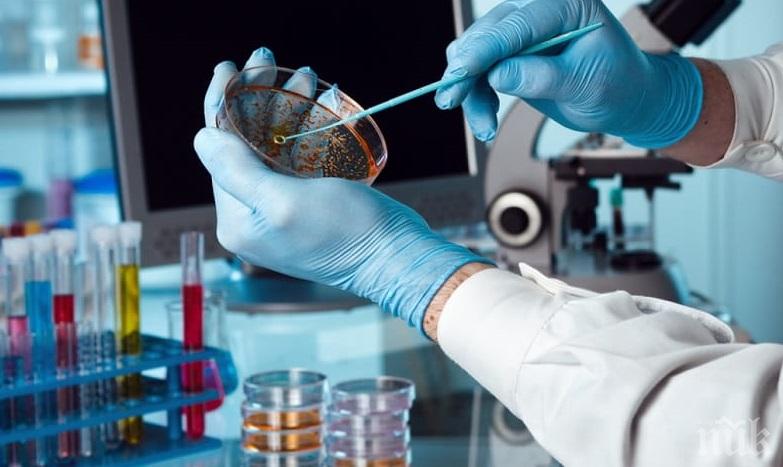
Голяма новина! Всички стволови клетки на фалиралата CryoSave се съхраняват безопасно в Полша

Голяма новина! Всички стволови клетки на фалиралата CryoSave се съхраняват безопасно в Полша
ПИК с нов канал в Телеграм
Последвайте ни в Google News Showcase
Всички стволови клетки на българските семейства от фалиралата швейцарска тъканна банка CryoSave се съхраняват в лабораториите на тъканната банка PBKM FamiCord Group, Полша. Това заяви Баран Томаш, директор „Продажби и маркетинг“ и член на борда на директорите на PBKM FamiCord Group. Контейнерите с биологичния материал на почти всички клиенти на CryoSave са безопасно транспортирани до лабораториите на PBKM FamiCord Group в Европа, предимно във Варшава и сега основно се съхраняват в най-голямата тъканна банка в полската столица.
„Ние гарантираме, че по време на прехвърлянето, което беше под наблюдението на група експерти, са спазени всички стандарти и изисквания за транспортиране на биологичен материал“, каза Баран Томаш. Решението за прехвърляне на материала е взето от CryoSave. Материалът беше прехвърлен в PBKM FamiCord Group като част от договора за безопасно съхраняване на биологичен материал, сключен между двете компании, за да се предостави на клиентите непрекъсната и висококачествена услуга. „CryoSave решиха да поверят тази услуга на нашата банка поради факта, че PBKM FamiCord Group се счита за най-надеждната сред европейските тъканни банки, с високи стандарти за съхранение и дългогодишното ни много добро финансово състояние“, обясни Баран Томаш.
„Нашият приоритет е да гарантираме безопасността и правилните условия за съхранение на CryoSave пробите, защото знаем колко трудна е ситуацията за родителите и не искаме да предадем тяхното доверие. На първо място, трябва да се подчертае, че детето е единственото лице, което има право да изхвърля биологичния материал (т.е. проби, съхранявани в клетъчната банка). До навършване на пълнолетие на детето, решението за изхвърляне на биологичния материал се взема от законните му настойници (обикновено родителите). По-специално, родителите могат да решат в коя банка да се съхраняват пробите или да ги изхвърлят. Решението е само на родителите какво да правят с договора с CryoSave и какво да правят с биологичния материал на детето си. Те имат пълно право да променят тъканната банка, в която се съхраняват такива проби“, посочи Баран Томаш.
Поради фалита на CryoSave ние препоръчваме на родителите да сключат договор с PBKM FamiCord Group, тъй като само в този случай можем да гарантираме приемането на по-ранните плащания от тяхна страна. До сключването на нов договор, PBKM FamiCord Group ще съхранява проби без договор, уреждащ въпроса за възнаграждението. Разбира се, в такава ситуация PBKM FamiCord Group ще издава проби на клиента при поискване, но може да изиска от клиента да възстанови пазарните разходи за издаване на пробите.
За да подпишат договор с PBKM FamiCord Group, родителите трябва да направят две стъпки: Първо трябва да се регистрират и да поискат PBKM FamiCord Group да потвърди за пробите им на следния линк https://famicord.eu/contact/for-cryo-save-client. Компанията в момента проверява целия инвентар, като досега 45% от него е физически проверен. Ако пробата вече е идентифицирана, родителите ще получат потвърждение в рамките на 1-2 седмици. Ако пробата все още не е идентифицирана - трябва да изчакат. Целият процес по инвентаризация ще бъде завършен в рамките на 10-15 седмици. Втората стъпка е подписване на договор с PBKM FamiCord Group, който може да се сключи онлайн на https://client.famicord.eu
С цел да се стимулират клиентите да сключват договор с FamiCord - плащанията, извършени от българските семейства до CryoSave, ще бъдат напълно признати от FamiCord Group и клиентът ще трябва да плати друга такса едва след края на периода, предплатен на CryoSave, само ако желае да продължи съхранението, подчерта Баран Томаш. Например, в случай, че някой е сключил договор с Cryo-Save през 2007 г. за 20 години, ние ще пазим пробата безплатно до 2027 г. Ако сте платили за повече от 20 години за съхранение, можем да поискаме доказателство за това. Ще бъдете задължени да заплатите друга такса само след края на периода, предплатен на CryoSave. От наша гледна точка можем да сключим споразумението, зачитайки 20 години от неговото подписване, също и в случай, че не са извършени всички плащания. FamiCord Group ще пази пробата безплатно дотогава. Така семействата, които са сключили договор през 2018 г. с възможност за съхранение от 20 години, но са платили част от вноските, ще получат оферта за безплатно съхранение до 2038 г. Тези условия са в полза на клиентите, които могат да се свържат с компанията чрез специална форма за контакт, но тя си запазва правото да ги променя.
Важно е да се каже, в случай че пробата е необходима за лечение, от FamiCord Group могат да я идентифицират от 1 до 3 дни. Вече е правено за няколко семейства, които са клиенти на CryoSave. Те подписаха специално споразумение с нас, което позволи изпращането на материали от лабораторията на FamiCord до центъра за трансплантация. Освободихме пробите въз основа на нашите процедури с одобрението на нашия медицински директор и ги изпратихме за лечението в САЩ за наша сметка, заяви Баран Томаш. Ако трябва да използвате биологичния си материал, моля да пишете на компанията възможно най-скоро, за да можем да Ви съдействаме в процеса и да Ви предоставим цялата необходима помощ. „Стволовите клетки са все по-важни и ние вярваме в бъдещото развитие на медицината. Всички проби дават допълнителен шанс за лечение сега или в бъдеще“, отбеляза Баран Томаш.
PBKM FamiCord Group е най-голямата банка за стволови клетки в Европа и една от петте най-големи в света. Съхранява над 440 000 различни проби на стволови клетки на над 300 000 семейства. Присъства пряко или косвено в Унгария, Испания, Италия, Португалия, Швейцария, Полша, Румъния, Турция, Египет, Сърбия, Хърватия, Словения, Черна гора, Босна и Херцеговина, Албания, Косово, Северна Македония, Латвия, Украйна, Дания, Литва, Швеция, Великобритания, САЩ и др. Работи и съхранява проби в 10 лаборатории, които са разположени в Полша, Швейцария, Германия, Португалия, Унгария, Испания и др. Лабораторията в Полша е една от най-големите в света в сектора на тъканните банки за стволови клетки и притежава акредитации на национални, международни органи и много известни институции, включително Американската асоциация на кръвните банки (AABB), ISO, TUV.
PBKM FamiCord Group е единствената тъканна банка в Европа, която е контролирана от големите си финансови акционери като AOC (Германия), Nationale Netherlanden, Esaliens, Петролен фонд на Норвегия, Invesco (САЩ), Rockbridge, Allianz и много други институции от САЩ, Германия, Швейцария, Япония и Полша.





































